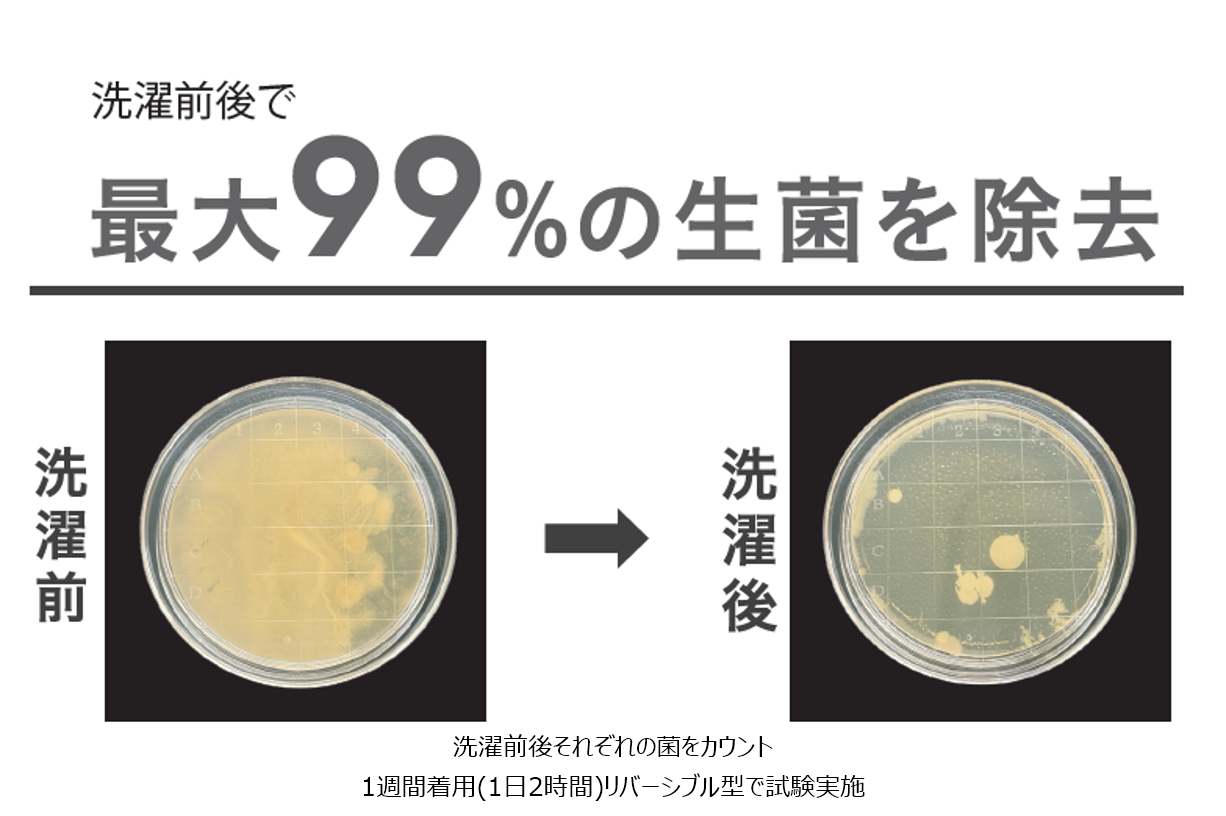

マシンウォッシャブルを可能にしたニット帽「Pure Deo」秋冬シーズンの新作としてベイシアより新発売
~ 秋冬のおしゃれアイテムにおすすめ ~

商品特徴
①お手入れらくらく!マシンウォッシャブル機能
「洋服と同じように、帽子も洗えたほうが清潔で長く使えて良い」という観点から、マシンウォッシャブルに着目。ご自宅の洗濯機で洗っても縮みにくく、最大99%の菌を除去※できる仕様に設計しました。これまで、型崩れの懸念や手洗いの面倒さから敬遠していた方にもおすすめです。
※商品自体に抗菌等の機能はありません
②ユニセックスで使いやすいカラー展開
今回のラインナップは2パターン合計で8カラー展開。性別を問わず、どなたでもお使いいただけます。また、ニット帽特有のチクチク感や窮屈さを感じさせず、暖かくて柔らかい着用感を重視した商品※です。
※個人差があります
商品概要

商品名:Pure Deo(ピュアデオ)
売価:全アイテム780円(税込価格858円)
素材:アクリル100%
展開カラー
リブ型:ピンク・グレー・茶・黒
リバーシブル型:ブルー・Lピンク・アイボリー・ベージュ
展開店舗 以下63店舗
<福島県>
白河モール店、安達店
<新潟県>
新潟豊栄店、小千谷店
<茨城県>
玉造店、古河総和店、潮来店
<栃木県>
矢板店、烏山店、さくら氏家店、益子店、那須塩原店、真岡店、大平モール店
<群馬県>
大間々店、吉井店、尾島店、榛名店、渋川店、西部モール店、前橋ふじみモール店、渋川こもち店、富岡店、
前橋モール店、安中店、吾妻店、月夜野店、おおたモール店、前橋みなみモール店、大泉店
<埼玉県>
寄居店、寄居北店、鶴ヶ島店、栗橋店、ひだかモール店、なめがわモール店、本庄早稲田ゲート店
<千葉県>
鴨川店、富里店、佐倉店、市原八幡店、長生店、大網白里店、ちば古市場店、野田さくらの里店、東金店、
いすみ大原店、木更津金田店、千葉ニュータウン店、勝浦店、成田芝山店
<東京都>
青梅インター店
<山梨県>
山梨店
<長野県>
更埴店、飯山店、あづみの堀金店、東御店
<静岡県>
浜松都田テクノ店
<愛知県>
三好店、名古屋みなと店
<岐阜県>
関店
<滋賀県>
彦根店、甲賀店
ベイシアは、生活に「価値」を提供できる商品やサービスの提案を通して、今後もお客様の日常に寄り添いながら多くの方に喜んでいただけるよう進化を続けてまいります。
このプレスリリースには、メディア関係者向けの情報があります
メディアユーザー登録を行うと、企業担当者の連絡先や、イベント・記者会見の情報など様々な特記情報を閲覧できます。※内容はプレスリリースにより異なります。
すべての画像
